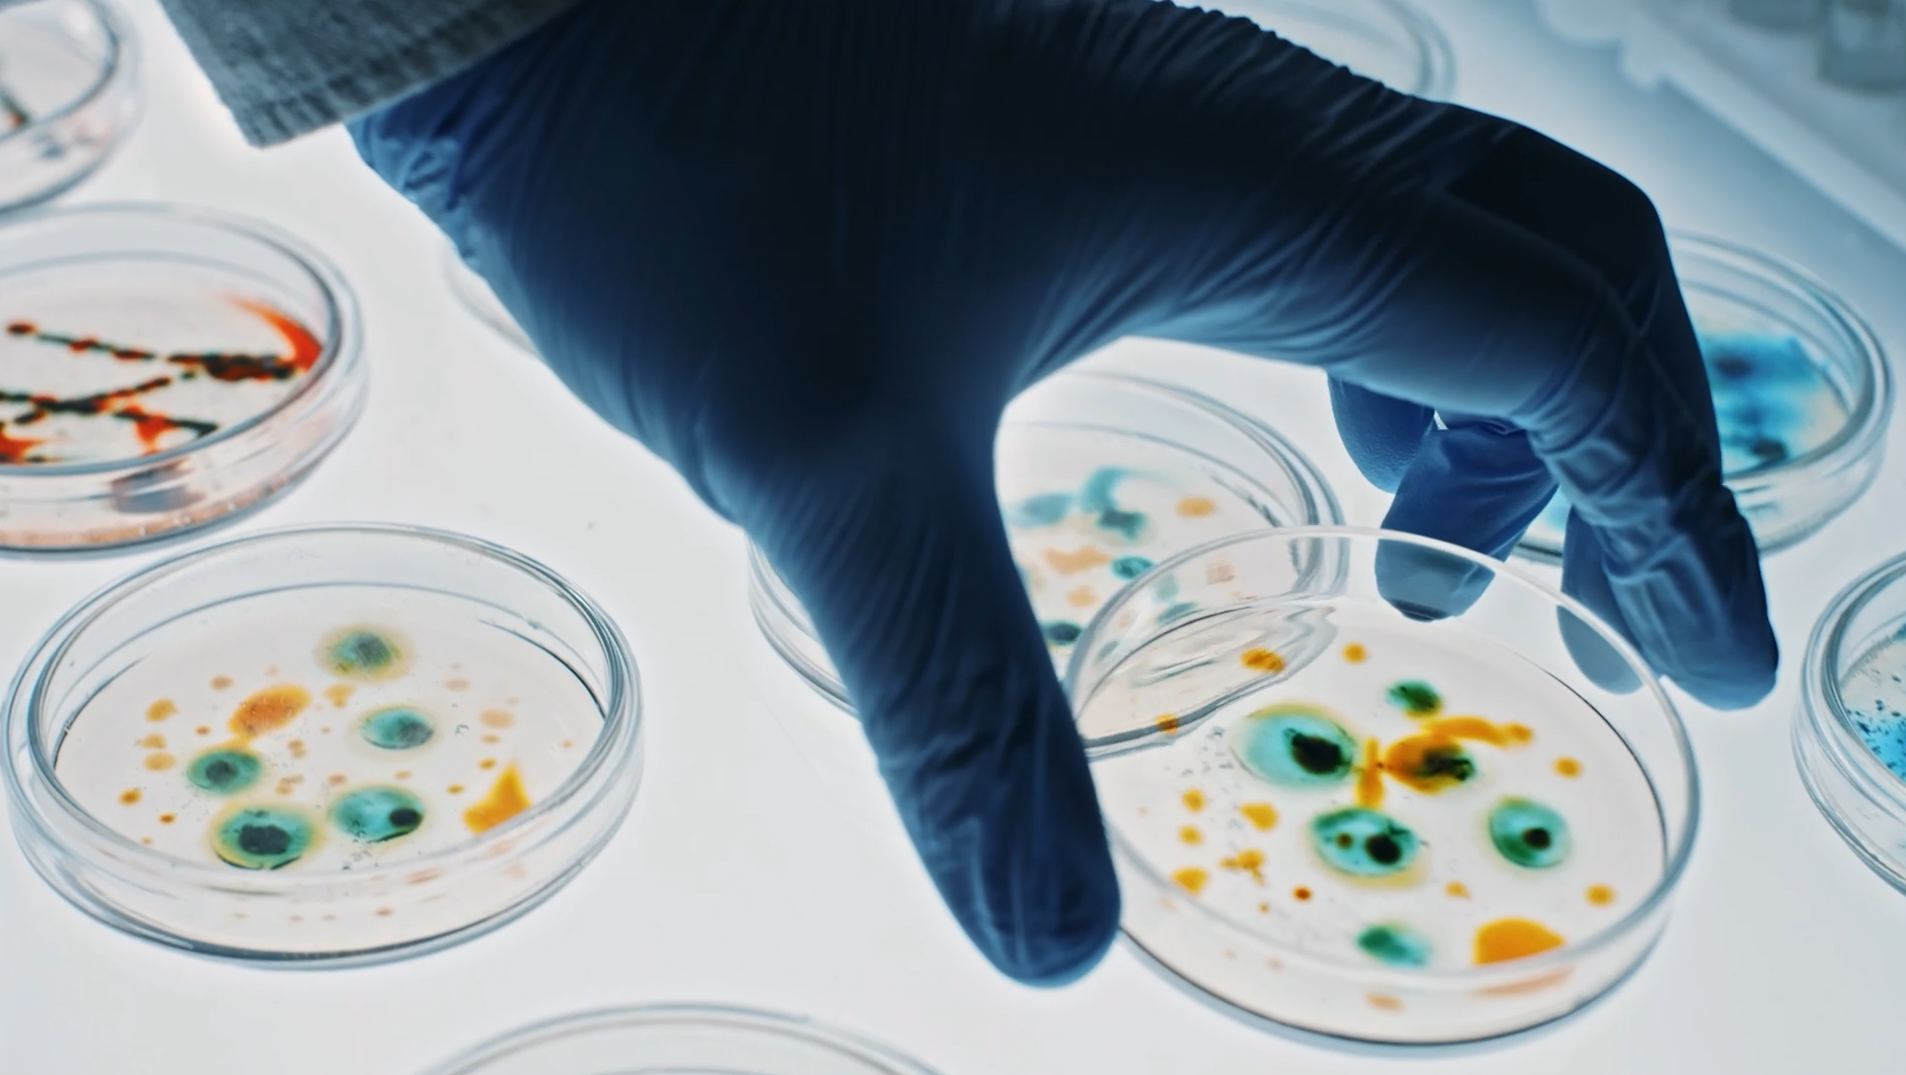
Vitrology Banner V1 Thumbnail

Comprehensive range of expert-led biopharmaceutical testing services – from early cell bank safety assessment and product characterization to phase appropriate method development and validation, bioanalysis and final GMP product release.
Rapid advances are being made in biopharmaceutical, cell and gene therapies. Our comprehensive range of cutting-edge biopharmaceutical testing solutions support you and your evolving needs.
We offer innovative biopharmaceutical testing, biosafety, bioanalytics and product quality control solutions for every lifecycle stage – from early phase cell bank safety assessment and product characterization to later phase method development, bioanalysis and final phase product release.
We are recognized as an industry pioneer, a reputation underpinned by our bioanalytical team’s active pursuit of assay development and validation for innovative biomarkers. We have an extensive range of validated assays spanning cell-based and immunoligand-based assays and offer a full range of potency assay test methods.
Our services are overseen by highly skilled analysts, who offer rapid high-volume analyses using a range of innovative techniques. As a trusted partner, we provide flexible business development solutions that best suit the needs of your business and your patients.
Looking for something specific?
Search within Biopharmaceutical Services
616 Heathrow Drive,
Lincolnshire, Illinois, 60069,
United States